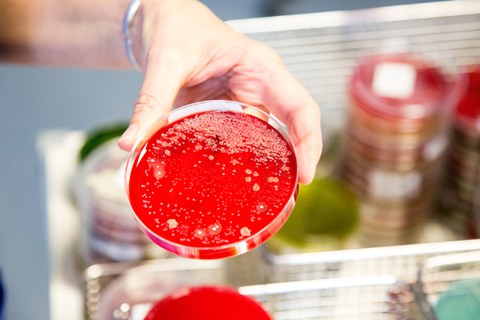
Institut für Virologie

Oct 16, 2020
Die Kugel ins Rollen gebracht
Blick durch den Laborautomaten der der Firma BD Kiestra™, der in seiner modularen Bauweise so noch einzigartig ist. Foto: Hochschulmedizin Dresden/Stephan Wiegand
Das Institut für Mikrobiologie, Virologie und Hygiene der Dresdner Hochschulmedizin startet in eine neue Ära der mikrobiologischen Laboranalyse und investiert in den neuen Laborautomaten der Firma BD Kiestra™. Er erleichtert das Anlegen von Bakterienkulturen, verkürzt die Zeit der Auswertung und erhöht so die Sicherheit für die Patienten.
Dresden, 16. Oktober 2020. Um Bakterienkulturen auf Nährböden zu züchten, ist auch heute noch viel Handarbeit nötig. Die codierten Probenröhren werden einzeln aufgeschraubt, eine Öse taucht in die Probe und wird von den Mitarbeitern gleichmäßig auf der mit einem Nährmedium versehenen Petrischale ausgebracht. Sie arbeiten dabei in verschiedenen Quadranten und verfolgen das Ziel, die Bakterien möglichst zu vereinzeln. Mehrere hundert Mal muss eine Technische Assistentin diese Handgriffe pro Tag machen. Das kostet wertvolle Zeit und soll sich nun am Institut für Mikrobiologie, das zur Medizinischen Fakultät der TU Dresden gehört, ändern.
Professor Alexander Dalpke, der das Institut seit Januar 2019 leitet, möchte die Prozesse vermehrt automatisieren, um die Mitarbeiter zu entlasten und zeitliche Kapazitäten für die Auswertung der bakteriellen Kulturen zu schaffen. Deshalb hat sich das Institut für Mikrobiologie zu einer Investition im sechsstelligen Bereich entschlossen. Der Medizingerätehersteller BD liefert mit dem Anlageautomat BD Kiestra™ InoqulA™ einen neuen Typ einer bereits bewährten Automatenreihe. Das Besondere ist die modulare Bauweise des Analysegerätes. „Wir gehen mit dieser Investition schon einen großen Schritt in Richtung Automatisierung. Was noch fehlt und was sich noch ergänzen ließe, ist die Automatisierung von Transport und Bebrütung der Proben“, so Prof. Dalpke. Auf diesen finalen Schritt muss im Institut aus baulichen Zwängen heraus bislang verzichtet werden – durch den modularen Aufbau können weitere Geräte aber später ergänzt werden.
Und dennoch, der Anlageautomat wird die Abläufe massiv verändern. Er ermöglicht die vollautomatisierte Verarbeitung eines Großteils der mikrobiologischen Proben, in einer Umgebung, in der mit einer speziellen Filtertechnik mögliche Verunreinigungen ausgeschlossen werden. Die Proben werden dazu in Probenständer gestellt. Für ihre Auswertung stehen zwölf verschiedene Nährmedien parallel zur Verfügung, die unterbrechungsfrei nachgeladen werden können. Proben werden automatisch aufgeschraubt und die Entnahme erfolgt mittels einer Pipette. Diese bringt einen einzigen Tropf auf das jeweilige Nährmedium. Die Verteilung übernimmt eine Rolling Bead, eine magnetische Perle. Die kleine, nur wenige Millimeter große, Kugel wird über einen Magneten gesteuert und nach einem definierten Muster über die Petrischale geführt. Sie legt dabei einen Weg von bis zu vier Metern zurück und vereinzelt die Bakterien. „Das erledigt der Automat viel gleichmäßiger als das auch bei noch so geübter Handarbeit möglich wäre“, sagt Prof. Dalpke. Und das hat Folgen für die Auswertung. Müssen heute noch etwa zehn Prozent aller händisch erstellten Proben abgeimpft, also neu ausgestrichen werden, weil im ersten Anlauf die Vereinzelung der Bakterien nicht glückte, rechnet Prof. Dalpke künftig mit einer Rate, die gegen Null geht. Außerdem können Bakteriengemische besser untersucht werden. Das bringt entscheidende Vorteile für den Patienten, denn jedes Abimpfen bedeutet weitere 24 Stunden Wartezeit auf ein Analyseergebnis. So aber verkürzt sich die Zeit bis die Laborergebnisse vorliegen erheblich, es kann schneller eine Diagnose gestellt und die passende Behandlung eingeleitet werden.
Der Automat des international tätigen Medizintechnikunternehmens BD ermöglicht es auch, Bouillons und Objektträgern zu beimpfen. Besonders dringliche Proben können in der Einzelausgabe bearbeitet werden und auch nicht flüssige Proben lassen sich halbautomatisiert verarbeiten. „Unser Ziel ist es, die Abläufe im klinischen Alltag und damit die Versorgung der Patienten zu verbessern“, sagt Prof. Alexander Dalpke. Und er ergänzt: „Mit dem neuen Laborautomat werden unsere Laborkräfte in die Lage versetzt, Krankheiten schneller und genauer zu diagnostizieren, gleichzeitig können wir Forscher bei der Entwicklung neuer Diagnose- und Behandlungsmöglichkeiten unterstützen.“
Die Investition war schon länger geplant. Denn die Zahl der Proben wächst. Allein in den letzten zwei Jahren verzeichnen Prof. Dalpke und seine Kollegen einen Zuwachs um jährlich sechs Prozent auf zuletzt 14.000 Proben monatlich. „In dieser Zeit von der Handarbeit wegzukommen und die Bakterienkulturen automatisch anlegen zu können, ist ein richtiger und wichtiger Schritt“, so Professor Michael Albrecht, der Medizinische Vorstand des Uniklinikums Dresden. „Auch wenn der Fokus der vergangenen Wochen vor allem auf dem Coronavirus lag, gibt es tagtäglich viele hundert Bakterienkulturen aus dem Uniklinikum selbst und Arztpraxen, die schnell und zuverlässig ausgewertet werden müssen. Die modulare Lösung in Dresden ist bisher einmalig in Deutschland. Sie wird mit Hilfe der hier gesammelten Erfahrungen weiterentwickelt werden“, ergänzt der Medizinische Vorstand, Prof. Albrecht. „Das Analysegeräte wird aber nicht nur in der aktuellen Diagnostik eine wesentliche Rolle spielen, sondern auch bei der Erforschung neuer Behandlungsmethoden und ihrer Wirksamkeit“, ergänzt Professor Heinz Reichmann, Dekan der Medizinischen Fakultät der TU Dresden. Das Analysegerät wurde in den letzten Wochen in Dresden eingebaut, eingerichtet und wird heute offiziell in Betrieb genommen.
Fakten:
Die Laborautomatisierung in der klinischen Mikrobiologie ist ein vergleichsweise junges Feld, erst in den letzten 20 Jahren hat sich hier etwas getan. Die ersten BD Kiestra™ Laborautomationslösungen für die Mikrobiologie wurden 2006 installiert. Heute stehen Automaten stehen in den Unikliniken in Jena, Heidelberg oder Graz.
Der Analyseautomat in Dresden ist 4,3 Meter lang, 0,94 Meter breit und 1350 Kilogramm schwer. Pro Stunde ist er in der Lage, bis zu 220 Proben zu beimpfen. Das Institut für Mikrobiologie geht davon aus, dass zunächst rund 600 Proben pro Tag bearbeitet werden.
Die magnetische Perle entspricht in ihrer Struktur einem Tennisball. Sie ist sehr klein, leicht und verfügt über eine raue Oberfläche, um das Probenmaterial optimal aufnehmen zu können.
BD ist eines der weltweit führenden Medizintechnikunternehmen, das 1897 in Franklin Lakes (News Jersey) gegründet wurde und in fast allen Ländern der Erde vertreten ist, BD hat weltweit 65.000 Mitarbeiter, in Deutschland sind etwa 1800 Mitarbeiter tätig.
Kontakt:
Institut für Medizinische Mikrobiologie und Hygiene
Institut für Virologie
Professor Alexander Dalpke
Facharzt für Mikrobiologie, Virologie und Infektionsepidemiologie, Fachimmunologe (DGfI)
Tel: +49(0)351 458 6550
BD
Dr. Emanuel Clausing
Senior Marketing Manager Integrated Diagnostic SolutionsTel. +49(0)305 389
Mail: emanuel.clausing@bd.com
